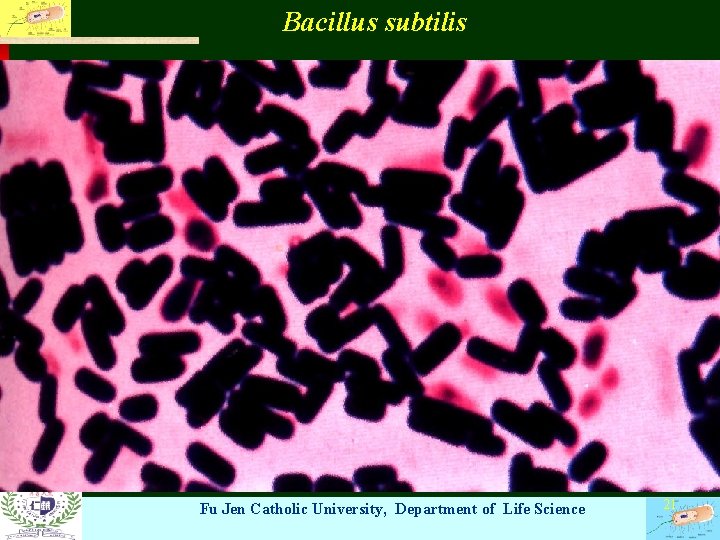
Bacillus subtilis Fu Jen Catholic University, Department of Life Science 21
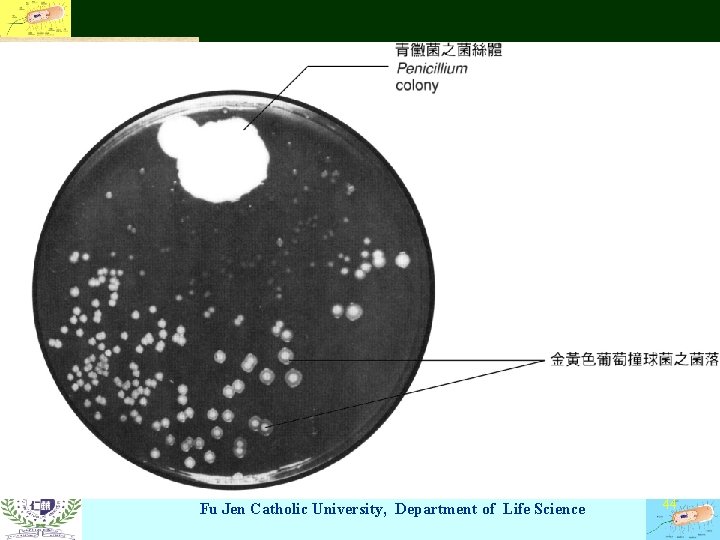
Fu Jen Catholic University, Department of Life Science 44

Introduction and History Microbiology Microorganism Microbes animalcules Definition

Introduction and History • • Microbiology Microorganism: 主要之研究對象 Microbes: animalcules Definition: 無法以肉眼看到之微小生物 • Microscope: Anton van Leeuwenhoek magnifying glasses Fu Jen Catholic University, Department of Life Science 1

Fu Jen Catholic University, Department of Life Science 2

Anton van Leeuwenhoek (1632 -1723) Fu Jen Catholic University, Department of Life Science 3

Fu Jen Catholic University, Department of Life Science 4

• Fu Jen Catholic University, Department of Life Science 5

Discovery of microbial world • Origin of microorganisms • Spontaneous generation 自然發生說 • organisms arise from nonliving matter----Francesco Redi • 腐肉生蛆 • John Needham • Abbe Lazzaro Spallanzani Fu Jen Catholic University, Department of Life Science 6

Francesco Redi Fu Jen Catholic University, Department of Life Science 7

Biogenesis • Louis Pasteur—the father of Microbiology A French chemist disprove the spontaneous generation swan-necked flasks • John Tyndall-English physicist hay infusion heat-resistant forms---endospore Fu Jen Catholic University, Department of Life Science 8

Swan-necked flasks Fu Jen Catholic University, Department of Life Science 9

Fu Jen Catholic University, Department of Life Science 10

The golden age of microbiology • Began in 1857 to the 20 th century for 60 years • The work of Louis Pasteur 1. Pasteurization wine fermentation yeast cells and bacteria germ theory of disease Fu Jen Catholic University, Department of Life Science 11

Louis Pasteur (1822 -1895) Fu Jen Catholic University, Department of Life Science 12

Pasteur and diseases • Isolation 隔離法 • Vaccination 預防注射 vaccine 疫苗 vaccinia virus 牛痘病毒 • Biogenesis Fu Jen Catholic University, Department of Life Science 13

Fu Jen Catholic University, Department of Life Science 14

Robert Koch • Anthrax 炭疽病 • Bacillus anthracis • Koch’s postulates • Cultivation techniques • Pure culture 純培養 Fu Jen Catholic University, Department of Life Science 15

Koch’s postulates Fu Jen Catholic University, Department of Life Science 16

Joseph Lister Fu Jen Catholic University, Department of Life Science 17

Characteristics of microorganisms • • Prokaryotes (pro= primitive) 原核生物 Eukaryotes (eu=true) 真核生物 1. bacteria 細菌 Rickettsiae 立次菌 Chlamydiae 披衣菌 Mycoplasmas 黴漿菌 Cyanobacteria 藍菌 Fu Jen Catholic University, Department of Life Science 18

Fu Jen Catholic University, Department of Life Science 19

Micrococcus luteus and Bacillus cereus Fu Jen Catholic University, Department of Life Science 20
Bacillus subtilis Fu Jen Catholic University, Department of Life Science 21

Scope of Microorganisms • • 2. Fungi 真菌 --eukaryotes 3. Protozoa 原生動物--eukaryotes 4. Unicellular algae 藻類--eukaryotes 5. Viruses 病毒 Fu Jen Catholic University, Department of Life Science 22

Cyclotella meneghiniana – an algae Fu Jen Catholic University, Department of Life Science 23

Tetrahymena pyriformis– a protozoa Fu Jen Catholic University, Department of Life Science 24

Crithidia luciliae-flagellate protozoan Fu Jen Catholic University, Department of Life Science 25

General properties of microorganisms • Origin of classification--- taxonomy 3 Kingdoms—Plant, Animal, Protist • Modern classification Robert H. Whittaer in 1969 Five-Kingdom system—Monera, Protista, Fungi, Plantae, Animalia Fu Jen Catholic University, Department of Life Science 26

Bacterial Taxonomy • Bergey’s Manual of Systematic Bacteriology • Nomenclature—binomial system 二名法 (bi-nomial=two names) Escherichia coli or Escherichia coli E. coli 大腸桿菌 Bacillus subtilis or B. subtilis 枯草桿菌 Fu Jen Catholic University, Department of Life Science 27

Five-Kingdom system Fu Jen Catholic University, Department of Life Science 28

Size Relationships • The unit of length: micrometer, μm Protozoa 100 μm Virus 0. 01 μm Fungi 10 -40 μm Bacteria 1 -5 μm Rickettsiae 0. 5 μm Chlamydiae 0. 25 μm Fu Jen Catholic University, Department of Life Science 29

Size comparison Fu Jen Catholic University, Department of Life Science 30

Microscopy • Light microscope 光學顯微鏡 bright-field microscope compound microscope oil-immersion microscopy • • Dark-field microscope 暗視野顯微鏡 Phase-constrast microscope 位像差顯微鏡 Fluorescent microscope 螢光顯微鏡 Electron microscope 電子顯微鏡 Fu Jen Catholic University, Department of Life Science 31

Bright-field Phase-contrast Dark-field Interference contrast Fu Jen Catholic University, Department of Life Science 32

Electron Microscope • TEM 穿透式電子顯微鏡 Transmission Electron Microscope • SEM 掃描式電子顯微鏡 Scanning Electron Microscope Fu Jen Catholic University, Department of Life Science 33

TEM SEM Fu Jen Catholic University, Department of Life Science 34

Fu Jen Catholic University, Department of Life Science 35

E. coli Fu Jen Catholic University, Department of Life Science 36

Staphylococcus aureus 金黃色葡萄狀球菌 Fu Jen Catholic University, Department of Life Science 37

Streptococcus pyrogenes 化膿性練球菌 Fu Jen Catholic University, Department of Life Science 38

Poliovirus– a virus Fu Jen Catholic University, Department of Life Science 39

Aspergillus flavus – a fungus Fu Jen Catholic University, Department of Life Science 40

Fu Jen Catholic University, Department of Life Science 41

Special fields of Microbiology • • Immunology 免疫學 Virology 病毒學 Chemotherapy 化學療法 Genetics 遺傳學 Molecular Biology 分子生物學 Genetic Engineering 基因 程學 Biotechnology 生物技術學 Fu Jen Catholic University, Department of Life Science 42

DNA double helix Fu Jen Catholic University, Department of Life Science 43
Fu Jen Catholic University, Department of Life Science 44

The scope of Microbiology • Basic Microbiology • Applied Microbiology Fu Jen Catholic University, Department of Life Science 45

Basic Microbiology • • • Morphology, Structure Nutrition, Growth, Metabolism Control Genetics Host-microbe interaction Fu Jen Catholic University, Department of Life Science 46

Applied Microbiology • • Medical Microbiology Food Microbiology Industrial Microbiology Environmental Microbiology Soil Microbiology Water Microbiology Air Microbiology Fu Jen Catholic University, Department of Life Science 47
- Slides: 47